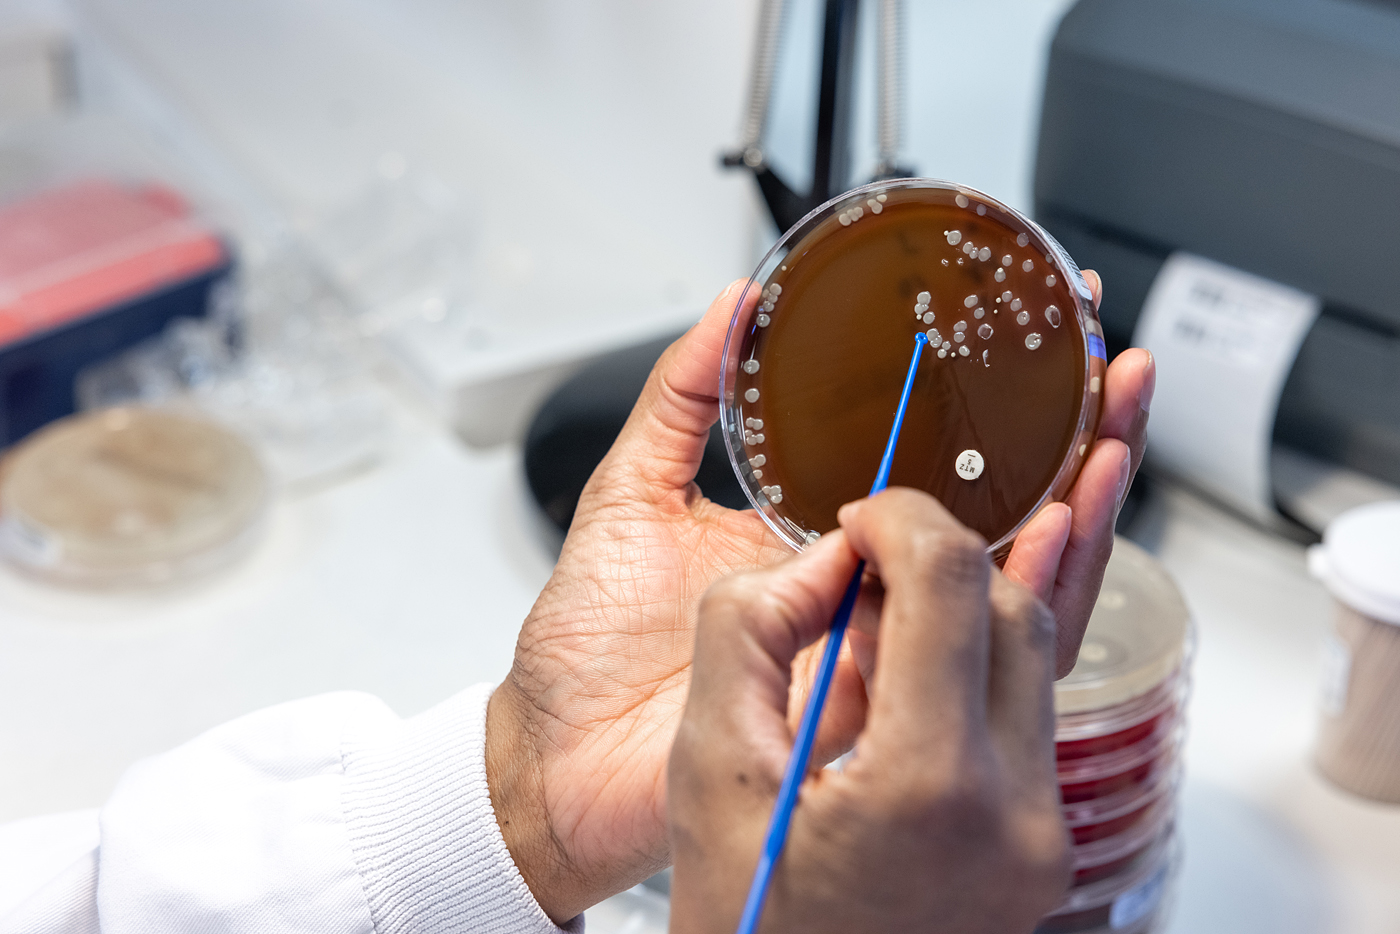
Kiestra Microbiology Lab - Hands and Agar Plate

Become a virologist
Virology is all about understanding viruses – from more common infections such as chicken pox to new and emerging infections like Zika and Ebola. Virologists are medical doctors that oversee the diagnosis, management and prevention of infection. They’re also scientists, who may drive research on various aspects of viruses. A virologist may be both a scientist and a physician. They mix their time between working at the bench in laboratories and providing advice to staff across many different areas of the human and animal health service sectors.
Virologists are responsible for diagnosing viral infections and also investigate the pharmacological response of viruses to antiviral drugs and the evolution of drug resistance. They give expert advice to colleagues on hospital wards and to veterinarians, as well as to government. They also advise GPs on how antiviral drugs should be prescribed and used appropriately. They’re often involved in directly managing patient care, especially of people with persistent infections including HIV and persistent viral hepatitis.
Virologists also work in public health and health protection medicine and may be required to give advice on immunisation and vaccine use. When there is a viral outbreak on a ward, virologists work together with the hospital’s infection control team, advising staff on the ward on the extent of transmission and how to limit further infection.
It is my job to act as a conduit between the virology laboratory and the clinicians looking after patients.

What will my working environment be like?
As a virologist, you’ll be expected to learn about how viruses spread, how to isolate them, and how to diagnose, treat and prevent infections. Virologists spend part of their time in microbiology or virology laboratories. Indeed, they work in many different types of laboratories. For example, in the research laboratory, they use genetic characterisation to identify novel or emerging agents, which enable them to develop diagnostic assays that can be used to help define the spread of infection in both humans and animals.
Because many different people need a virologist’s expertise, they work closely with a wide variety of medical staff. They advise other doctors over the phone, attend multidisciplinary meetings, and visit staff and patients in wards, clinics and A&E. They may even work internationally, for example with the World Health Organization, and be involved in global health problems. Virologists also teach trainees and are involved in research.
What skills do I need?
- An analytic and inquisitive mind – you need to be able to interpret accurately a range of different tests and their results, and take a critical view on all investigations.
- Calm under pressure – you’ll need to be adept at dealing with changing priorities, from re-emerging threats to seasonal flu. If incidents increase in your community or hospital ward, work can become pressurised and unpredictable.
- Good communication skills – you’ll work with many people at various levels in hospitals, public health and other sectors, so being able to share clear knowledge and advice is vital.
How will I train?
To become a medical virologist, you’ll need to complete:
- undergraduate training at medical school
- the UK foundation training programme or equivalent
- Core Medical Training (CMT) or Acute Care Common Stem (ACCS) training
- specialty training in infections and medical virology.
You can also choose to specialise in infectious diseases and tropical medicine.
